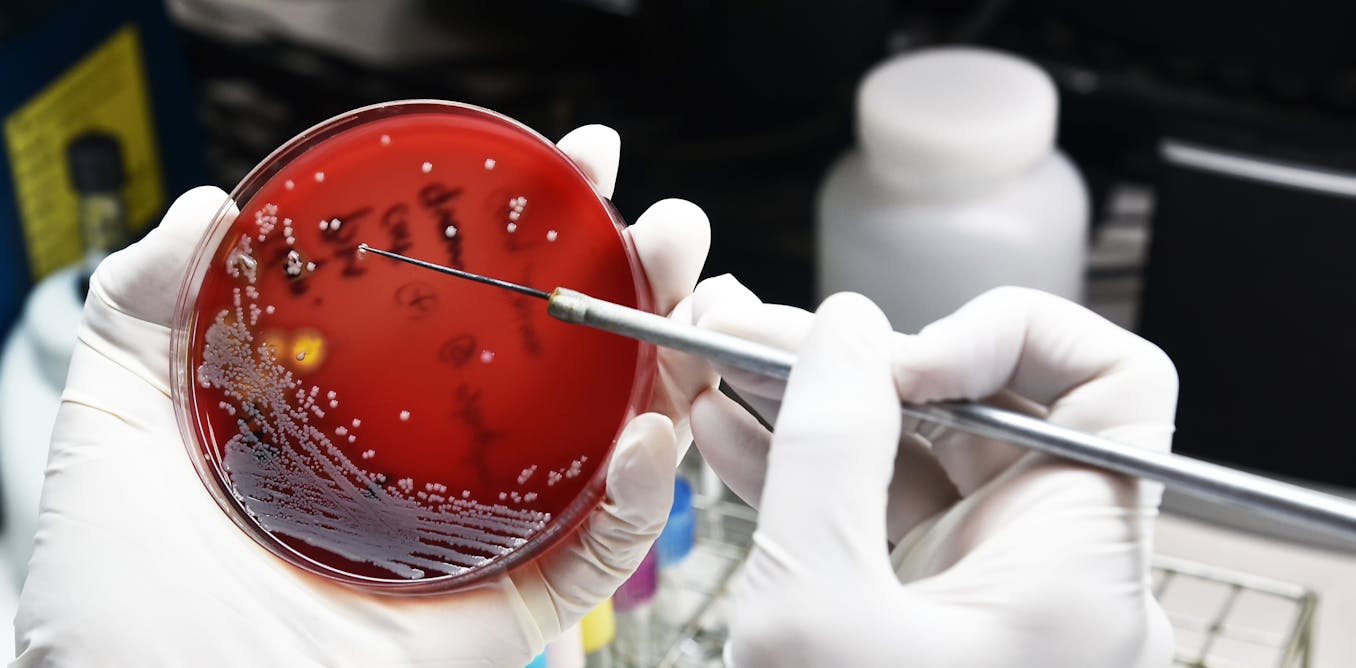

CEO Picks - The best that international journalism has to offer!
S6422 Years Later, One of the Best Strategy Games Ever Made Just Got a Massive Update   There are few things as satisfying as seeing your painstakingly-designed castle operate flawlessly, turning away a siege while your cheese farms and bow-makers churn away endlessly. Real-time strategy (RTS) games have been highly influenced by a few key titles, such as Starcraft and Age of Empires. However, there’s another less-known classic that’s equally as influential: Stronghold.
Continued here
|
S1
S2Do You Understand Why You Catastrophize?   Leaders who create doomsday scenarios out of everyday setbacks — what behavioral scientists call “catastrophizing” — risk spreading their anxiety to their teams. In this article, the author digs in to the psychological and physiological reasons behind this tendency to draw disastrous conclusions and presents several ways to address it: 1) Reflect on how you learned to expect the worst; 2) Create ways to interrogate faulty data; 3) Learn to regulate amid your catastrophizing; 4) Separate fears rooted in reality from those you fabricate; and 5) Acknowledge the consequences your catastrophizing has for others.
Continued here
|
S3The Ambidextrous Organization   This mental balancing act is one of the toughest of all managerial challenges—it requires executives to explore new opportunities even as they work diligently to exploit existing capabilities—and it’s no surprise that few companies do it well. But as every businessperson knows, there are companies that do. What’s their secret?
Continued here
|
S4AI Ethics at Unilever: From Policy to Process | Thomas H. Davenport and Randy Bean   Our special report on innovation systems will help leaders guide teams that rely on virtual collaboration, explores the potential of new developments, and provides insights on how to manage customer-led innovation.Our special report on innovation systems will help leaders guide teams that rely on virtual collaboration, explores the potential of new developments, and provides insights on how to manage customer-led innovation.Many large companies today — most surveys suggest over 70% globally — have determined that artificial intelligence is important to their future and are building AI applications in various parts of their businesses. Most also realize that AI has an ethical dimension and that they need to ensure that the AI systems they build or implement are transparent, unbiased, and fair.
Continued here
|
S5 The End of Averages for Marketing Budgets   Our special report on innovation systems will help leaders guide teams that rely on virtual collaboration, explores the potential of new developments, and provides insights on how to manage customer-led innovation.Our special report on innovation systems will help leaders guide teams that rely on virtual collaboration, explores the potential of new developments, and provides insights on how to manage customer-led innovation.In his 2015 book The End of Average, Todd Rose warns against “averagarians” designing systems based on the mean or judging success in terms of the deviation from the mean. He highlights Gilbert Daniels, an anti-averager hero, whose research in the 1950s led the U.S. Air Force to design planes with personalized cockpit features to suit pilots of all shapes and sizes rather than just the average male pilot — an innovation that dramatically increased safety records.
Continued here
|
S6How 'ESG' came to mean everything and nothing   In 2015, Paris was buzzing with anticipation as world leaders gathered for the UN's annual Climate Change Conference (COP21). After weeks of intense debate, on 12 December, they emerged with a promise: 196 nations pledged to take on climate change with the goal of net zero emissions by 2050. For businesses, this signalled the beginning of the "ESG" movement: a focus on environmental, social and governance issues in business decisions. Across the globe, companies rolled out individual, ambitious campaigns towards net zero objectives; ESG-focused investment strategies ranged, but often included transitions to green energy and divestment from fossil fuels.
Continued here
|
S7Napoleon review: Ridley Scott's biopic is 'an awe-inspiring achievement'   Martin Scorsese is 80 and Ridley Scott is nearly 86, but neither director is showing any signs of slowing down. In recent years, in fact, their films have grown longer, more expensive and more ambitious than ever. The latest example is Napoleon, Scott's 160-minute biopic of the French military commander and ruler, which sweeps through several countries and several decades, and has several thunderous battle scenes along the way. It's an awe-inspiring achievement, although it may leave you with a greater appreciation of Scott's leadership skills than of Napoleon's.More like this:- Was Napoleon really a monster? - 'Nicolas Cage at his darkly comic best' - Was Napoleon the greatest film never made?
Continued here
|
S8How to update your wardrobe easily and sustainably   For the past two years, Stephen Lehane has been running "stitch 'n' bitch" sessions from his flat in London. On a free Saturday, he'll announce the session to friends and family, who descend with items of clothing they'd like repaired or upcycled into something "new". Lehane has two conditions: people must stay while their clothes are being altered, and payment is a bottle of wine."I'll sit at my sewing machine all day while friends drop by with ripped leggings, dresses that are too tight or jeans that don't fit their style anymore," he explains. "The flat really comes alive, and there's such a lovely feeling of community that a fast-fashion retailer could never replicate. I make an effort to talk people through what I'm doing, so I can share some practical skills. I do warn that, as the day goes on and the wine flows, my 'creativity' soars. Don't arrive at 10pm and trust me to immaculately hem your wedding dress."
Continued here
|
S9Stents for angina have more than just a placebo effect, new trial confirms   Stents are like scaffolding that keep narrowed arteries open. These devices have been revolutionary in treating heart attacks where their use has increased year on year and countless lives have been saved. But the role of stents in patients with stable angina is less clear. Heart arteries are like motorways supplying blood to the heart muscle. When a heart artery is narrowed by atherosclerosis it is like reducing the number of lanes from three down to one. At night, when there aren’t many cars on the road, the traffic can get through without delay. But during rush hour, when there are greater demands on the network (an analogy for exercise), traffic jams occur. This explains why patients with stable angina only get chest pain when they exert themselves.
Continued here
|
S10 S11Henry Bredekamp and the Khoisan: the living legacy of a renowned South African historian   Bredekamp, who passed away in September 2023, was central in debunking this myth. Aside from his scholarship, he will be remembered for his influential role as a public historian and a conduit for the revival of Khoisan indigenous identity. Many within the movement fondly refer to him as the father of Khoisan revivalism. Read more: Rock art: how South Africa's coat of arms got to feature an ancient San painting
Continued here
|
S12 S13Scientists suspect there's ice hiding on the Moon, and a host of missions from the US and beyond are searching for it   Building a space station on the Moon might seem like something out of a science fiction movie, but each new lunar mission is bringing that idea closer to reality. Scientists are homing in on potential lunar ice reservoirs in permanently shadowed regions, or PSRs. These are key to setting up any sort of sustainable lunar infrastructure. In late August 2023, India’s Chandrayaan-3 lander touched down on the lunar surface in the south polar region, which scientists suspect may harbor ice. This landing marked a significant milestone not only for India but for the scientific community at large.
Continued here
|
S14 S15A TikTok Jesus promises divine blessings and many worldly comforts   The TikTok profile Daily Believer (@believerdaily) has 70 videos with computer-generated Jesuses looking directly at the viewer, beseeching them to stop scrolling and watch the next minute’s worth of content. All these Jesuses are long-haired and bearded, recalling artist Warner Sallman’s ubiquitous 1940 painting “Head of Christ.” Some wear the crown of thorns, some look alarmingly like the actor Jared Leto. Nearly all promise a surprise or “good news soon” in exchange for the viewer liking, commenting “Amen” or sharing it with their friends and family. With this digital outreach, the Daily Believer has gained, as of Nov. 13, 2023, 813,200 followers and over 9.2 million likes.
Continued here
|
S16As the US begins to build offshore wind farms, scientists say many questions remain about impacts on the oceans and marine life   As renewable energy production expands across the U.S., the environmental impacts of these new sources are receiving increased attention. In a recent report, the National Academies of Sciences, Engineering, and Medicine examined whether and how constructing offshore wind farms in the Nantucket Shoals region, southeast of Massachusetts, could affect critically endangered North Atlantic right whales. The Conversation asked marine scientists Erin L. Meyer-Gutbrod, Douglas Nowacek, Eileen E. Hofmann and Josh Kohut, all of whom served on the study committee, to explain the report’s key findings.The Bureau of Ocean Energy Management, which is part of the U.S. Department of the Interior and regulates offshore energy production, asked the National Academies to conduct this study. Regulators wanted to better understand how installing and operating offshore, fixed-bottom wind turbine generators would affect physical oceanographic processes, such as tides, waves and currents, and in turn how those changes could affect the ecosystem.
Continued here
|
S17From ancient Greece to Broadway, music has played a critical role in theater   Though anxiety about the fate of live theater performances still lingers, Broadway is celebrating its third season since reopening after the COVID-19 pandemic, with a lineup dominated once again by musicals. The new season includes long-running hits like “Hamilton,” revivals of classics like “Merrily We Roll Along,” new musical adaptations of nonmusical works like “Days of Wine and Roses,” and even “Here We Are”, the last musical by Stephen Sondheim.
Continued here
|
S18Poor men south of Richmond? Why much of the rural South is in economic crisis   For a brief moment in the summer of 2023, the surprise No. 1 song “Rich Men North of Richmond” focused the country’s attention on a region that often gets overlooked in discussions of the U.S. economy. Although the U.S. media sometimes pays attention to the rural South — often concentrating on guns, religion and opioid overdoses — it has too often neglected the broad scope and root causes of the region’s current problems.As economic historians based in North Carolina and Tennessee, we want a fuller version of the story to be told. Various parts of the rural South are struggling, but here we want to focus on the forlorn areas that the U.S. Department of Agriculture refers to as “rural manufacturing counties” — places where manufacturing is, or traditionally was, the main economic activity.
Continued here
|
S19As Lachlan Murdoch takes over from his father he may need to reset News Corp's relations with Donald Trump   As Rupert Murdoch hands over the reins of News Corp and Fox to his son Lachlan, there is an opportunity to rebuild the relationship between the family’s media empire and former US president Donald Trump. This would make business sense for Fox as Trump is a ratings winner. But it may prove to be more difficult than it first appears.The deterioration of the relationship between the Murdochs and the former president resulted in Trump choosing not to attend the Fox’s Republican debates. But Trump’s refusal to participate in any of the three debates has not affected his chances of gaining the nomination.
Continued here
|
S20Health risks at home: a study in six African countries shows how healthy housing saves children's lives   Housing is a critical social determinant of health. The World Health Organization (WHO) defines healthy housing as a shelter that supports physical, mental and social wellbeing. The WHO has developed guidelines outlining the attributes of healthy housing. These include structural soundness, as well as access to a local community that enables social interactions. Healthy housing protects inhabitants from the effects of disasters, pollution, waste and extreme heat or cold. It provides a feeling of home, including a sense of belonging, security and privacy.
Continued here
|
S21AI is already being melded with robotics - one outcome could be powerful new weapons   Interest in the incorporation of robots into security, policing and military operations has been steadily increasing over the last few years. It’s an avenue already being explored in both North America and Europe.Robot integration into these areas could be seen as analogous to the inclusion of dogs in policing and military roles in the 20th century. Dogs have served as guards, sentries, message carriers and mine detectors, among other roles.
Continued here
|
S22Homeless mothers in England spend up to   When women with children are made homeless – usually by either rent arrears, after no-fault evictions or domestic violence – they are often moved into temporary accommodation. The latest figures from the Department for Levelling Up, Housing and Communities reveal there are presently 104,510 households and 131,000 children living in temporary accommodation in England. Sometimes this lack of a permanent place to call home is not so temporary. In Greater Manchester, specifically, homeless families spend on average two years in temporary accommodation. During that period, they can be moved multiple times, at very short notice and across boroughs.
Continued here
|
S23How the Welsh language is being promoted to help migrants feel at home   The UK government alone decides who can enter the country and how migration and asylum policies are made. But devolved governments have scope to use their powers in fields such as housing, education, health and social services to shape the nature of the support that is subsequently offered to new arrivals.In recent years, the Welsh government has looked for ways to use its powers to help refugees and migrants integrate into Welsh society, taking into account the role of the Welsh language.
Continued here
|
S24The Doomsday Clock warns the world about catastrophe - here's why it stands at 90 seconds to midnight   The Doomsday Clock, with its hands hovering close to midnight (“doomsday”), is a symbolic device that is designed to warn the world how close it is to catastrophe. Midnight is said to represent the point at which the Earth becomes uninhabitable by humanity.The clock dates back to the early days of the cold war. It was set up as an integral feature of a journal called the Bulletin of Atomic Scientists. This was established in 1947 by those Manhattan Project scientists and engineers who were closely linked to the development of the atomic bomb. They were concerned about “the destroyers of worlds” they had created. Articles in the bulletin were largely devoted – as they still are today – to highlighting the perils of nuclear weapons.
Continued here
|
S25Saltburn: why you should read Brideshead Revisited by Evelyn Waugh, the book that inspired the new film   Ever since I first read Evelyn Waugh’s Brideshead Revisited as a master’s students many years ago, I have been smitten. Literary trends and fashions come and go, but I still return to Brideshead every couple of years for sheer reading pleasure.Undoubtedly Waugh’s most famous novel, Brideshead Revisited was first published in 1945 after the second world war. Its narrative is deeply imbued with nostalgia for an unspoilt, quasi-mythical rural England of stately homes and bright young upper-class people that, it can be argued, never really existed in the first place.
Continued here
|
S26Compassion fatigue can happen to anyone -- here's how you can overcome it   When tragic events happen, no matter how far away from us they are, it’s hard not to pay attention. Many of us empathise with the people in these situations and wonder how we can get involved, or if there’s anything we can do to help.Over the past few years, we’ve borne witness to a series of pivotal global events, from the COVID pandemic to Russia’s invasion of Ukraine, as well as many natural disasters. Just when it seemed that things could not get worse, last month conflict in Gaza escalated.
Continued here
|
S27Podcast listener survey: _Don't Call Me Resilient_   If you have listened to our podcast, Don’t Call Me Resilient, we’d like to know more about you and what you like (or don’t like) about it. Our survey will only take about 10 minutes of your time, and will help us further shape the podcast with you — our audience — always in mind
Continued here
|
S28 S29 S30 S31 S32How a new identity-focused ideology has trapped the left and undermined social justice   Deputy Director, Institute for Ethics, Governance & Law. President, Australian Association for Professional & Applied Ethics., Griffith University Yasha Mounk’s new book, The Identity Trap: A Story of Ideas and Power in Our Time, explores a radical progressive ideology that has been taking the world by storm. From its unlikely beginnings in esoteric scholarly theories and niche online communities, this new worldview is reshaping our lives, from the highest echelons of political power to the local school classroom.
Continued here
|
S33 S34Infrastructure review recommends culling 82 planned projects   The Albanese government’s infrastructure review has recommended 82 projects should be cancelled, after finding the $120 billion program unsustainable in its current form. Construction has not started on these projects. The review recommends the savings be used to provide “headroom” in the program which is facing a large cost overrun.
Continued here
|
S35What exactly is a ceasefire, and why is it so difficult to agree on one in Gaza?   Barely a week after Hamas’ attack on Israeli soldiers and civilians on October 7 and the subsequent airstrikes by the Israeli Defence Force on the Gaza Strip, talk of a ceasefire had already begun.More than five weeks into the war, calls for a ceasefire have only grown louder. Visiting the White House this week, Indonesian President Joko Widodo said, a “ceasefire is a must for the sake of humanity.”
Continued here
|
S36Long hours and low wages: the human labour powering AI's development   The Finnish tech firm Metroc recently began using prison labour to train a large language model to improve artificial intelligence (AI) technology. For 1.54 euros an hour prisoners answer simple questions about snippets of text in a process known as data labelling.Data labelling is often outsourced to labour markets in the Global South where companies can find workers who are fluent in English and willing to work for low wages.
Continued here
|
S37What designers can do to make textiles healthier for people and the planet   The pollution caused by the textile industry is often discussed, but its impact on health is less emphasized. Nevertheless, the petrochemical compounds used in the manufacturing of our clothes have harmful effects on workers, surrounding communities, and consumers. This issue has a global impact, but its assessment is complex due to our low chronic exposure to a “cocktail” of synthetic substances whose cause-and-effect relationships are difficult to identify.Moreover, most of these substances prove to be toxic through interaction or degradation, as is the case with azo dyes that are ubiquitous and persistent in the environment.
Continued here
|
S38 S39Does screen use really impact our thinking skills? Our analysis suggests it could   Screens have become seamlessly integrated into our daily lives, serving as indispensable tools for work, education and leisure. But while they enrich our lives in countless ways, we often fail to consider the potential impact of screen time on our cognitive abilities.In a new meta-analysis of dozens of earlier studies, we’ve found a clear link between disordered screen use and lower cognitive functioning.
Continued here
|
S40What Joe Biden's meeting with Xi Jinping means for geopolitical tensions   U.S. President Joe Biden has engaged in a crucial face-to-face meeting with Chinese President Xi Jinping at the Asia-Pacific Economic Cooperation (APEC) summit in San Francisco.This high-stakes diplomatic encounter was aimed at alleviating tensions between the world’s two superpowers. The meeting carried immense significance as leaders of the world’s largest economies seek to establish a sense of stability following a challenging year in U.S.-China relations.
Continued here
|
S41Curious kids: what are tummy rumbles?   There are a few different reasons for “tummy rumbles” or the (sometimes weird) noises your stomach makes. For the most part, these are part of the normal workings of not only your stomach, but also your intestines. These are parts of your digestive system, which kicks into gear when you eat. It breaks down (digests) food and then the nutrients are absorbed by the body. Whatever is left comes out as poo (also called faeces).
Continued here
|
S42Biden-Xi meeting at APEC a reminder of the importance of global summits in dangerous times   For three decades, the leaders of the Asia Pacific Economic Cooperation (APEC) forum have met to advance their shared interests in improving trade and investment across the region. This year’s meeting in San Francisco has a particular prominence. US President Joe Biden and his Chinese counterpart Xi Jinping have met for the first time since last year’s G20 summit in Bali, amid efforts by the two great powers to improve their fraught relationship. APEC is normally held alongside the annual ASEAN and East Asia summits, but those jamborees were held a little earlier this year, giving the trans-Pacific grouping some much-needed clear air.
Continued here
|
S43 S44As school students strike for climate once more, here's how the movement and its tactics have changed   On Friday, students will once again down textbooks and laptops and go on strike for climate action. Many will give their schools a Climate Doctor’s Certificate signed by three leading climate academics. These strikes – part of a National Climate Strike – mark five years since school students started walking out of schools to demand greater action on climate change. In 2018, the first students to strike defied calls by then prime minister Scott Morrison for “less activism” and to stay in school.
Continued here
|
S45Creative minds are vulnerable to mental illness - but magicians escape the curse   Can you think of a comedian, actor, poet or writer who suffered from mental illness? Maybe the actor Robin Williams or comedian Stephen Fry came to your mind. Perhaps it was the writer Virginia Woolf. All three have had well-documented struggles with bipolar disorder.Mental illnesses have been associated with creative thinking for a long time. For instance, mathematician John Nash’s battle with schizophrenia was immortalised in the film A Beautiful Mind (2001).
Continued here
|
S46Engineered stone kills tradies. Bunnings and IKEA stopping its sales is a big win for public health   Major retailers Bunnings and IKEA have announced this week they will discontinue selling engineered stone. While this might mean you have to rethink your plans for your new kitchen benchtops, it’s a positive step that will protect the health of tradespeople exposed to this dangerous product.Engineered stone contains up to 95% crystalline silica dust. This superfine dust is released into the atmosphere when workers cut, grind or drill engineered stone.
Continued here
|
S47 S48 S49Grattan on Friday: A government in a big hurry gives opposition some wins on ex-detainees   It’s not very often we see a bill marched through parliament at such a pace as this week. After being caught on the hop by the High Court, the government has brought in emergency legislation to strengthen its powers to control more than 80 people, some of them serious criminals, it has been forced to release from immigration detention. The bill was introduced in the lower house on Thursday morning and passed the parliament Thursday night.
Continued here
|
S50Insects are spreading a devastating plant disease in Italy - Britain must keep it out   Since 2013, over 20 million olive trees in Italy have succumbed to a devastating plant disease. The same disease now threatens many more plant species, across several countries, with the same fate. During spring, gardeners will often wonder why blobs of spit-like foam have suddenly appeared on their favourite plants. Many will think them unsightly, perhaps even taking time to wash them off, only for the foam to appear again the next day.
Continued here
|
S51 S52 S53Why the Pyrenees' mountain lakes are turning green   Directeur de recherche CNRS, Expert for Conservation Biology, Axa Chair for Functional Mountain Ecology at the École Nationale Supérieure Agronomique de Toulouse, Centre national de la recherche scientifique (CNRS) I first set foot in the Pyrenees in 2006. Two years later, I began a large-scale survey of mountain lakes and amphibian populations: from east to west, I covered more than 100 mountain lakes located in the eastern Pyrenees to the Béarn region (Pyrénées-Atlantiques).
Continued here
|
S54Job hunting: why taking regular breaks is vital for your well-being and success   In many activities in life, including studying, working, or even job hunting, people need to take regular breaks in order to replenish their energy levels.Taking regular breaks can have a restorative effect not only in a professional context, but also for other important life tasks. One such activity is searching for a job, something that all of us have to face many times in the course of our lives.
Continued here
|
S55Antibiotic resistance: microbiologists turn to new technologies in the hunt for solutions - podcast The rise of drug-resistant infections is one of the biggest global threats to health, food security and development. Antibiotic-resistant superbugs were estimated to kill 1.27 million people in 2019, and the UN projects that drug-resistant diseases could cause 10 million deaths a year by 2050. In this episode of The Conversation Weekly podcast, we hear from a microbiologist at a hospital in Nigeria working on the frontlines against antibiotic resistance, and find out about the new scientific techniques, including artificial intelligence (AI), being deployed to find new potential antibiotics.
Continued here
|
S56We've Been Wrong to Worry About Deepfakes (So Far)   Deepfakes, videos generated or manipulated by artificial intelligence, allow people to create content at a level of sophistication once only available to major Hollywood studios. Since the first deepfakes arrived, seven years ago, experts have feared that doctored videos would undermine politics, or, worse, delegitimize all visual evidence. In this week's issue of The New Yorker, Daniel Immerwahr, a professor of history at Northwestern University, explores why little of this has come to pass. As realistic as deepfakes can be, people seem to have good instincts for when they are being deceived. But Immerwahr makes the case that our collective imperviousness to deepfakes also points to a deeper problem: that our politics rely on emotion rather than evidence, and that we don't need to be convinced of what we already believe.You can read Daniel Immerwahr's essay in The New Yorker's first-ever special issue about artificial intelligenceâout now.
Continued here
|
S57Hostage-Taking and the Use of Children and the Vulnerable in War   On October 7, 1985, in Alexandria, Egypt, four armed members of a faction of the Palestine Liberation Front boarded the Achille Lauro, an Italian cruise ship that was touring the Mediterranean. The hijackers seized the ship’s captain, herded passengers into a dining room, and declared that unless Israel released fifty Palestinian prisoners by three o’clock that afternoon they would start executing hostages. When the deadline passed without satisfaction, the hijackers separated Leon Klinghoffer, a sixty-nine-year-old Jewish American whose history of strokes had left him mostly confined to a wheelchair. They moved Klinghoffer to a deck outside, where Youssef Majed Molqi, the hijacking team’s leader, shot him in the head and chest. Molqi then ordered two of the ship’s crew to throw Klinghoffer’s body and wheelchair into the sea.Klinghoffer’s murder became an infamous touchstone in the nineteen-eighties era of made-for-TV hijackings, a time when armed liberation movements in the Middle East demonstrated the asymmetric power of spectacular mass hostage-taking. Terrorists of that era wanted “a lot of people watching, not a lot of people dead,” as the RAND Corporation analyst Brian Jenkins put it in 1974, because they sought to call attention to their cause without alienating sympathizers. Yet hijackers also singled out Jews and Americans for death as a form of strategic communication. As Molqi later testified at trial, after he was captured, “I chose Klinghoffer, an invalid, so that they would know that we had no pity for anyone, just as the Americans, arming Israel, do not take into consideration that Israel kills women and children of our people.”
Continued here
|
S58Is "The Golden Bachelor" Too Good to Be True?   Reality television is all about artifice, and contestants on "The Bachelor" often seem more interested in becoming influencers than in finding a spouseâbut "The Golden Bachelor," a new spinoff starring a seventy-two-year-old widower named Gerry, has been hailed for its surprising sincerity. On this episode of Critics at Large, the staff writers Vinson Cunningham, Naomi Fry, and Alexandra Schwartz discuss how the show eschewsâand, at times, reinforcesâthe tropes that have polarized viewers of the ABC franchise, and what a genre known for its phoniness can reveal about actual human emotions and experiences. The hosts consider other depictions of sex and romance at this stage of life, including Philip Roth's memorable rendering of an older man's libido in "The Dying Animal" and HBO's "And Just Like That . . . ," a rare look at older women's erotic prospects. Then, they take a step back to examine how series like "The Bachelor" have shaped our conception of love stories writ large. "The Golden Bachelor" 's insistence on the vitality of its contestants can feel like a step forward, but what does it mean that the show is so fixated on what Schwartz calls "a second teen-agerdom"? "The boomers set a model for what it is to be young that persists for all the generations that have followed," she says. "Now here they are again, saying, 'We're here; yes, we're older; and we want to get old in our own way.' "By signing up, you agree to our User Agreement and Privacy Policy & Cookie Statement. This site is protected by reCAPTCHA and the Google Privacy Policy and Terms of Service apply.
Continued here
|
S5930 Years Ago, Star Trek's Smartest Show Pushed the Sci-Fi Franchise Into Shocking Territory   In the eighth episode of Star Trek: The Next Generation, “Justice,” Wesley Crusher is sentenced to death on an alien planet for what the Enterprise crew views as a light misdemeanor. In a typically clunky Season 1 of TNG way, “Justice” demonstrated the difficulty of navigating interstellar laws as peacekeeping diplomats, but Wesley’s crime clearly reads as a trivial mistake that shouldn’t result in his execution.Six years later, Star Trek was exploring new frontiers with Deep Space Nine, in which Starfleet inherited a static outpost from imperialist Cardassians and worked alongside the newly liberated Bajoran people. Several of its early episodes felt like evolutions of trivial TNG ones, with these unofficial updates showing the series’ keenness to grapple with the more complicated side of cosmic exploration.
Continued here
|
S6010 Years Ago, PlayStation Dealt a Devastating Blow to Its Fiercest Rival   In the summer of 2014, Sony published a very strange video to YouTube. The 20-second clip features two PlayStation executives standing awkwardly in a dark room while holding a copy of the forgettable video game Killzone: Shadowfall.“This is how you share your games on PS4,” says gaming industry legend Shuhei Yoshida while mean-mugging the camera. He then hands Killzone to game developer-turned-executive Adam Boyes, who also stares straight into the camera and shouts, “Thanks!”
Continued here
|
S61Does 'The Marvels' Retcon 'Secret Invasion'?   If you had the unfortunate pleasure of watching Secret Invasion this past summer, then going to see The Marvels may prove to be a truly confounding experience for you. The new Marvel Cinematic Universe film is, to be clear, fine. It’s got a great, fun opening and the rest of it is forgettable at best. Compared to Marvel’s other 2023 movies, it sits comfortably in between the effectively bittersweet Guardians of the Galaxy Vol. 3 and the abominable Ant-Man and the Wasp: Quantumania.Regardless of what The Marvels may or may not get right, though, one thing the film definitely doesn’t do is acknowledge Secret Invasion. The new film zips through its story as if the universally derided Disney+ series never happened. On the one hand, that’s understandable. On the other hand, it’s hard to watch The Marvels and not be left scratching your head over the numerous ways that it either contradicts or outright ignores Secret Invasion. It’s a film that will leave you genuinely wondering whether or not Marvel Studios has already retconned the series from MCU canon.
Continued here
|
S62'Super Mario RPG' Remake Review: Nintendo Delivers a Mediocre Remaster of a Great Game   As I finally finished stomping on the sentient wedding cake, I couldn’t help but think that after nearly 27 years, there’s still nothing quite like Super Mario RPG, a fascinating fusion of Mario and Final Fantasy that would turn into a genre-defining experience.Super Mario RPG set the stage for so many games that would come after it, including Paper Mario and Mario & Luigi: Superstar Saga. And while it’s undoubtedly one of the most important RPGs ever made, Nintendo’s newly released remake is more of a 1:1 remaster than a true remake. There’s nothing inherently wrong with this new version of Super Mario RPG, but some of the game’s design flaws and problems are more apparent. While the brilliance of the original still shines through, I continuously found myself wishing more was changed and reimagined.
Continued here
|
S63'Bouncing' Comets Could Be Seeding Life Across The Universe   Huddled planets may have the skills to lasso comets — and perhaps get life to emerge, according to a new study.Earth was a cauldron of chaos 4.5 billion years ago. Somehow, it seeded life. And when it did, Earth emerged as a singular place amongst the planetary throng, at least as far as the Solar System is concerned.
Continued here
|
S65How Felicia Day Turned a Gig Into Her Newest Geeky Obsession   “I have a lot of different things that I do,” Day tells Inverse. “A lot of them, they start as hobbies and they become my profession.” The actor and author doesn’t need to show just how many hobbies she has — chatting on Zoom in front of an absolutely stuffed bookshelf, Day simply has to gesture behind her to prove that she’s made being a nerd her full-time job. “Behind me, I have lots of tabletop games, role-playing games, figurines, computer things,” she says.But in one particular instance, that process was reversed: An audiobook narration gig became a new obsession. After narrating the audiobook for Matthew Siege’s Rule of Cool, she discovered the world of literary RPGs — books replicating the feeling of RPGS complete with stats, leveling, magic systems, and worldbuilding. Commonly called litRPGs, they’re a fairly niche subsect of fantasy media. But for someone like Day with a proven pedigree in the roleplaying world, it might be the next step in the evolution of fantasy storytelling.
Continued here
|
S66Ridley Scott's Epic Vision Is No Match for Napoleon's Immense Legacy   The life of Napoleon proves too large for Ridley Scott to capture — at least with any sort of historical nuance.In a world where Hollywood blockbusters are dominated by tired franchises, Marvel metaverses, and schlocky horror slashers … one man has the experience and budget necessary to direct the ultimate historical epic. Indeed, at age 86, Ridley Scott is quite possibly the only man who could easily raise $200 million and brilliantly project modern history’s greatest battles onto an IMAX screen. That he can also attract the talents of a generational actor like Joaquin Phoenix — a man whose career he helped ignite two decades ago in Gladiator — should all but ensure a glorious outcome for Napoleon.
Continued here
|
S67Analogue's Modernized Game Boys Are a Blast From Nintendo's Past   I am so sorry that you will soon be broke after spending all of your savings on yet another limited edition drop of Analogue Pocket Game Boy handhelds.Analogue’s new set of “Classic” Pocket colors pay homage to official Game Boy Pocket and Game Boy Advance shades. Those colors are blue, green, indigo, Spice Orange, pink, red, silver, and yellow.
Continued here
|
S68 S69The Biggest Sci-Fi Movie of 2022 Just Got A Huge Upgrade   James Cameron has always insisted his films look the best they possibly can, from building huge sets to pioneering visual effect innovations. Naturally, both Cameron and his fans want his work to be viewable at home in the highest quality possible too, and now it’s finally possible to watch the majority of his work in 4K, including an upgraded version of his most recent and technically advanced movies.Lightstorm Entertainment, Cameron’s personal production company, has announced that six of Cameron’s films will be available in 4K via digital purchase and UHD Blu-Ray disc. The December 5 release of Titanic in 4K had already been announced, but that classic will now be joined by Aliens, The Abyss, True Lies, Avatar, and Avatar: The Way of Water.
Continued here
|
S70This Sounds Bad: Humane's Laser-Projecting Ai Pin Could Break From Sweat, Mist, or Condensation   Before general preorders for Humane’s hyped Ai Pin open up on November 16, there’s one detail you should know before you buy: the smartphone-replacing, laser-projecting, AI-talking wearable isn’t waterproof.According to a Humane support page: “For optimal performance, your Ai Pin and power accessories should not be exposed to water.” An earlier version of the page reportedly offered more details according to Reddit user r/jackylegz42. “This includes condensation, splashing, mist, and perspiration. Doing so would risk damage to your device and may void your warranty.” Humane seems to have removed the reference, though.
Continued here
|
| TradeBriefs Publications are read by over 10,00,000 Industry Executives About Us | Advertise Privacy Policy Unsubscribe (one-click) You are receiving this mail because of your subscription with TradeBriefs. Our mailing address is GF 25/39, West Patel Nagar, New Delhi 110008, India |